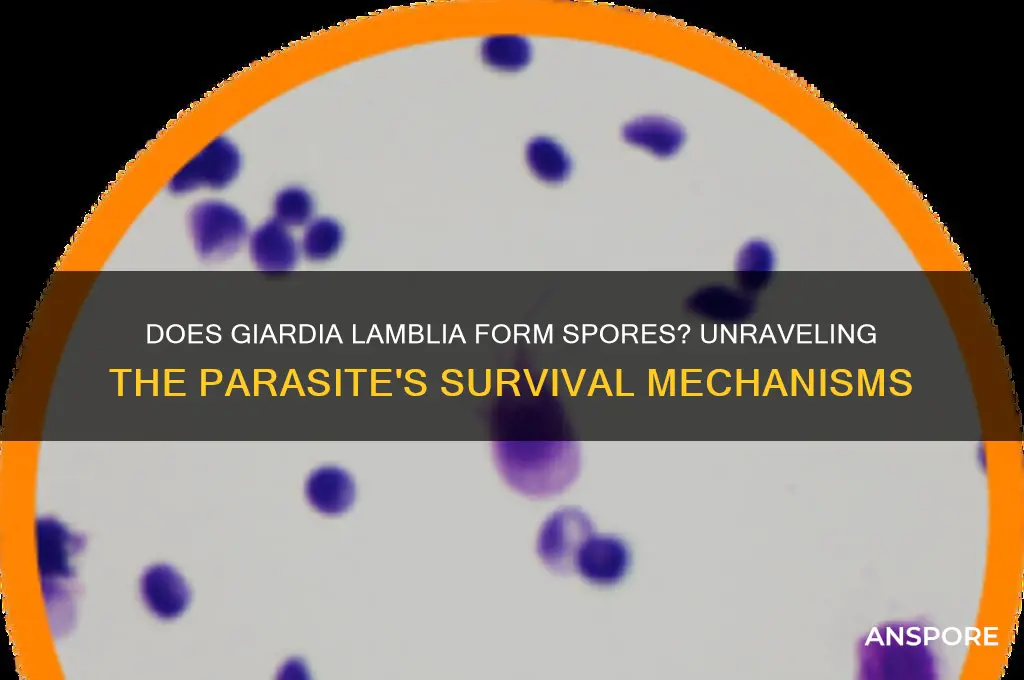
is giardia lamblia spore forming

Giardia lamblia, a common protozoan parasite, is frequently associated with waterborne gastrointestinal infections in humans and animals. One common question regarding its biology is whether it forms spores, a characteristic that would significantly impact its survival and transmission. Unlike spore-forming organisms such as certain bacteria and fungi, Giardia lamblia does not produce spores. Instead, it exists in two primary forms: the trophozoite, which is the active, feeding stage found in the intestines of infected hosts, and the cyst, a dormant, protective stage that is shed in feces and responsible for transmission. Understanding this distinction is crucial for comprehending Giardia's lifecycle, environmental persistence, and control strategies.
| Characteristics | Values |
|---|---|
| Spore Formation | No, Giardia lamblia does not form spores. |
| Life Cycle Stage Involved | Cysts are the infectious stage, not spores. |
| Cyst Characteristics | Hardy, oval-shaped, and can survive outside the host for weeks. |
| Transmission | Via fecal-oral route, often through contaminated water or food. |
| Survival in Environment | Cysts are resistant to chlorine disinfection but not to boiling water. |
| Disease Caused | Giardiasis, a gastrointestinal infection. |
| Host Range | Humans and other mammals. |
| Treatment | Antiparasitic medications like metronidazole or tinidazole. |
| Prevention | Improved sanitation, water treatment, and hygiene practices. |
What You'll Learn
- Life Cycle Stages: Giardia lamblia has two stages: trophozoite (active) and cyst (infective), but no spores
- Cyst Formation: Cysts are hardy, non-spore structures that survive outside hosts in harsh conditions
- Transmission Methods: Cysts spread via fecal-oral route, contaminated water, food, or surfaces, not spores
- Survival Mechanisms: Cysts resist environmental stresses without spore-like adaptations, ensuring long-term viability
- Misconceptions Clarified: Giardia lamblia does not form spores; cysts are often mistakenly called spores

Life Cycle Stages: Giardia lamblia has two stages: trophozoite (active) and cyst (infective), but no spores
Giardia lamblia, a microscopic parasite, navigates its life cycle through two distinct stages: the trophozoite and the cyst. Unlike some other pathogens, Giardia does not form spores, a fact that significantly influences its transmission and survival strategies. The trophozoite stage is the active, feeding form of the parasite, thriving in the small intestine of its host. This stage is responsible for the symptoms associated with giardiasis, such as diarrhea, abdominal cramps, and nausea. Understanding this phase is crucial for diagnosing and treating the infection effectively.
The cyst stage, on the other hand, is the infective form of Giardia. Cysts are hardy structures that can survive outside the host for extended periods, particularly in water sources. This resilience allows the parasite to spread efficiently, often through contaminated drinking water or food. When ingested, cysts excyst in the small intestine, releasing trophozoites and initiating a new infection cycle. This dual-stage life cycle highlights the parasite’s adaptability, but it also provides clear targets for prevention and intervention.
To break the cycle of Giardia transmission, focus on disrupting the cyst stage. Practical measures include boiling drinking water for at least one minute (three minutes at high altitudes) to kill cysts. For children and adults, proper hand hygiene after using the bathroom and before handling food is essential. In areas with known contamination, avoid consuming untreated water and unwashed produce. These steps are particularly critical for travelers visiting regions with poor sanitation.
Comparatively, spore-forming pathogens like *Clostridium difficile* have an additional survival mechanism, making them harder to eradicate. Giardia’s lack of spores simplifies its control, as cysts are more susceptible to environmental factors like heat and disinfection. However, this also means that prevention relies heavily on behavioral changes and water treatment. For instance, using water filters certified to remove cysts (e.g., those with a pore size of 1 micron or smaller) can be effective in high-risk settings.
In conclusion, while Giardia lamblia’s life cycle is limited to trophozoites and cysts, this simplicity offers opportunities for targeted prevention. By focusing on cyst inactivation and avoiding exposure, individuals and communities can significantly reduce the risk of giardiasis. This knowledge underscores the importance of water safety and hygiene in controlling this parasite, making it a manageable threat with the right strategies.
Optimal Spore Solution Dosage: How Much to Use Per Jar
You may want to see also

Cyst Formation: Cysts are hardy, non-spore structures that survive outside hosts in harsh conditions
Giardia lamblia, a microscopic parasite, employs a cunning survival strategy through cyst formation, a process that transforms it into a resilient, dormant structure capable of enduring harsh environments outside its host. Unlike spore-forming organisms, which undergo complex cellular changes to create highly resistant spores, Giardia cysts are simpler yet remarkably effective in their own right. These cysts are the parasite's ticket to survival in the external world, where they can persist for weeks to months in cold water, soil, or even on surfaces, waiting for an unsuspecting host to ingest them.
The formation of cysts is a critical phase in Giardia's life cycle, triggered when the parasite leaves the protective environment of its host's intestines. This transformation involves the parasite encysting itself within a protective wall, reducing its metabolic activity to a minimum. The cyst wall is composed of a tough, multilayered structure that shields the parasite from adverse conditions such as desiccation, extreme temperatures, and disinfectants. For instance, Giardia cysts can survive in chlorinated water, making them a significant concern for water treatment facilities. This resilience is particularly noteworthy given that cysts are not spores, which typically have even more robust protective mechanisms.
Understanding the durability of Giardia cysts is essential for preventing infection. These cysts are commonly found in contaminated water sources, including rivers, lakes, and poorly treated drinking water. They can also survive on food, especially raw produce irrigated with contaminated water. To mitigate the risk, it’s crucial to follow specific precautions: boil water for at least one minute (or three minutes at altitudes above 6,500 feet) to kill cysts, or use filtration systems certified to remove parasites. For travelers or hikers, portable water filters with a pore size of 1 micron or smaller are highly effective. Additionally, thorough washing of fruits and vegetables with clean water can reduce the risk of ingestion.
Comparatively, while spore-forming bacteria like Clostridium difficile can survive for years in spore form, Giardia cysts, though less enduring, are still formidable in their ability to persist in diverse environments. This distinction highlights the importance of targeted prevention strategies. Unlike spores, which may require extreme measures like autoclaving to destroy, Giardia cysts can be inactivated by relatively simple methods such as heat or filtration. However, their ability to survive in cold water for extended periods underscores the need for vigilance in water safety practices, especially in recreational water settings like swimming pools and hot tubs.
In practical terms, the hardy nature of Giardia cysts demands a proactive approach to public health. For instance, in outbreak scenarios, water treatment facilities may need to implement additional disinfection steps, such as ultraviolet (UV) light treatment or ozonation, to ensure cyst inactivation. Individuals, particularly those in high-risk groups like children, hikers, and international travelers, should be educated on the risks and preventive measures. Simple actions, such as avoiding swallowing water while swimming in natural bodies of water and practicing good hygiene, can significantly reduce the likelihood of infection. By focusing on the unique characteristics of cyst formation, we can better combat the spread of Giardia and protect vulnerable populations.
Alcohol's Effectiveness Against Fungal Spores: Survival or Elimination?
You may want to see also

Transmission Methods: Cysts spread via fecal-oral route, contaminated water, food, or surfaces, not spores
Giardia lamblia, a microscopic parasite, does not form spores. Instead, it relies on cysts for transmission, which are hardy, protective shells that encase the parasite in its dormant state. These cysts are the key players in the spread of giardiasis, a diarrheal illness that affects millions worldwide. Understanding how these cysts move from one host to another is crucial for prevention and control.
The primary route of transmission is fecal-oral, a direct yet often overlooked pathway. When an infected individual or animal passes cysts in their stool, these can contaminate water sources, food, or surfaces. Ingesting as few as 10 to 25 cysts can cause infection, making even minimal exposure a significant risk. For instance, swallowing contaminated water while swimming in a lake or river is a common scenario, especially in areas with poor sanitation. Backpackers and campers are particularly vulnerable, as untreated water from streams often harbors cysts.
Contaminated food is another critical vector, especially in settings where hygiene practices are inadequate. Fresh produce irrigated with contaminated water or handled by infected individuals can become a source of infection. Raw or undercooked foods pose the highest risk, as cooking typically destroys cysts. For example, a salad prepared with water tainted by cysts can easily transmit the parasite. To mitigate this, washing fruits and vegetables thoroughly with clean, safe water is essential. Peeling produce can also reduce risk, though it’s not always practical.
Surfaces in public spaces, such as doorknobs, toys, or bathroom fixtures, can become contaminated when touched by hands soiled with cysts. Young children, who frequently put objects in their mouths, are especially susceptible. Daycare centers and schools are high-risk environments due to close contact and less stringent hygiene practices among children. Regular handwashing with soap and water, particularly after using the toilet and before eating, is a simple yet effective preventive measure. Alcohol-based hand sanitizers are less effective against cysts, as they do not physically remove them from the skin.
Unlike spore-forming pathogens, which can survive extreme conditions for years, Giardia cysts are more fragile outside the host. They require moisture to remain viable, typically surviving for weeks in cool, damp environments but dying quickly in hot, dry conditions. This vulnerability highlights the importance of targeting transmission routes rather than the cysts’ longevity. By focusing on clean water, safe food handling, and hygiene, the spread of Giardia can be effectively controlled, even without the challenge of spore-like resilience.
Stanford's Intramural Sports Programs: Opportunities for Students to Get Active
You may want to see also

Survival Mechanisms: Cysts resist environmental stresses without spore-like adaptations, ensuring long-term viability
Giardia lamblia, a microscopic parasite causing gastrointestinal infections, does not form spores. Instead, it relies on cysts as its primary survival mechanism. These cysts are environmentally resilient structures that encapsulate the parasite, enabling it to withstand harsh conditions such as desiccation, temperature extremes, and chemical disinfectants. Unlike spore-forming organisms, which undergo complex cellular transformations, Giardia cysts maintain a simpler yet effective protective strategy. This distinction is crucial for understanding the parasite's persistence in water sources and its transmission dynamics.
Analyzing the cyst's structure reveals its adaptability. The cyst wall, composed of a thick, electron-dense layer, acts as a barrier against external stressors. This design allows cysts to remain viable for weeks to months in cold water, a key factor in their role as infectious agents. For instance, a study in the *Journal of Parasitology* found that Giardia cysts could survive up to 7 weeks in water at 4°C, highlighting their long-term viability without spore-like adaptations. This resilience underscores the importance of water treatment protocols, such as filtration and chlorination, to disrupt cyst integrity and prevent infection.
From a practical standpoint, understanding cyst survival mechanisms informs public health interventions. For individuals in areas with contaminated water sources, boiling water for at least 1 minute (3 minutes at altitudes above 6,500 feet) effectively inactivates cysts. Alternatively, portable water filters with a pore size of 1 micron or smaller can physically remove cysts. These measures are particularly critical for travelers, hikers, and communities lacking access to treated water. Unlike spore-forming pathogens, which may require more aggressive decontamination methods, Giardia cysts are susceptible to relatively straightforward interventions.
Comparatively, the absence of spore formation in Giardia lamblia contrasts with organisms like *Clostridium difficile*, which relies on spores for survival. While spores can endure extreme conditions for years, Giardia cysts are more vulnerable to heat and chemical treatment. However, their ability to persist in cool, moist environments makes them a persistent threat in natural water systems. This difference highlights the need for tailored control strategies: while spores demand high-temperature sterilization, cysts are effectively managed through filtration and moderate disinfection.
In conclusion, Giardia lamblia's cysts exemplify a survival mechanism that, while not spore-like, ensures long-term viability in diverse environments. Their resilience to environmental stresses, combined with susceptibility to specific interventions, provides a roadmap for prevention and control. By focusing on cyst-specific vulnerabilities, such as temperature sensitivity and physical filtration, public health efforts can effectively mitigate the risk of giardiasis. This nuanced understanding of cyst survival mechanisms is essential for safeguarding water supplies and protecting vulnerable populations.
Save Your Spore Creature as a PNG: Easy Steps Guide
You may want to see also

Misconceptions Clarified: Giardia lamblia does not form spores; cysts are often mistakenly called spores
Giardia lamblia, a common intestinal parasite, is frequently misunderstood when it comes to its reproductive forms. One pervasive misconception is that Giardia forms spores, a confusion often arising from the term "cysts," which are mistakenly labeled as spores. This error is not trivial; it can lead to incorrect treatment approaches and public health strategies. Understanding the distinction between cysts and spores is crucial for anyone dealing with Giardia infections, from healthcare providers to outdoor enthusiasts.
Analytical Perspective:
Giardia lamblia exists in two primary forms: trophozoites (the active, feeding stage) and cysts (the dormant, infectious stage). Cysts are hardy structures that allow the parasite to survive outside the host in harsh environments, such as contaminated water. Spores, on the other hand, are characteristic of certain bacteria and fungi, serving as a reproductive or resistant form. Giardia does not produce spores; its cysts are often misidentified due to their protective role and environmental resilience. This confusion likely stems from the superficial similarity in function—both cysts and spores enable survival outside a host—but their biological mechanisms differ fundamentally.
Instructive Approach:
To avoid this misconception, it’s essential to clarify terminology. Cysts are formed when Giardia trophozoites encyst within the host’s intestine, preparing for transmission. These cysts are then shed in feces and can contaminate water sources, food, or surfaces. When ingested, cysts excyst in the new host’s small intestine, releasing trophozoites that continue the life cycle. Spores, in contrast, are not part of Giardia’s life cycle. Educating individuals about these distinctions can prevent misinformation and ensure appropriate preventive measures, such as boiling water for at least 1 minute (3 minutes at altitudes above 6,500 feet) or using filtration systems with pore sizes of 1 micron or less.
Comparative Insight:
Unlike spore-forming organisms like Clostridium difficile, which produce endospores capable of withstanding extreme conditions, Giardia relies on cysts for transmission. While both cysts and spores serve protective functions, their structures and mechanisms differ. Spores are metabolically inactive and can remain viable for years, whereas Giardia cysts, though durable, are more susceptible to disinfection methods such as chlorination or iodine treatment. Recognizing this difference highlights the importance of targeted interventions: for example, while spores may require autoclaving for deactivation, Giardia cysts can be effectively removed through proper water filtration or chemical treatment.
Practical Takeaway:
For hikers, travelers, and caregivers, understanding that Giardia does not form spores is critical for prevention and treatment. Focus on cyst-specific measures: avoid drinking untreated water, practice good hygiene, and ensure proper sanitation. If infection occurs, antiparasitic medications like metronidazole (typically 250 mg three times daily for 5–7 days for adults) or tinidazole (2 g single dose) are effective against trophozoites and cysts. By dispelling the spore myth, individuals can adopt accurate, evidence-based strategies to manage and prevent Giardia infections, reducing the risk of transmission and complications.
Mastering Asymmetrical Spore Creation: Techniques and Tips for Unique Designs
You may want to see also
Frequently asked questions
No, Giardia lamblia does not form spores. Instead, it produces cysts, which are its infectious and environmentally resistant stage.
Giardia lamblia survives outside the host in the form of cysts, which are highly resistant to harsh environmental conditions, including chlorine in water.
Cysts are the dormant, protective form of Giardia lamblia, while spores are a distinct survival structure formed by other organisms, such as bacteria and fungi, to withstand extreme conditions.
Yes, boiling water for at least one minute effectively kills Giardia lamblia cysts, making it safe for consumption.

